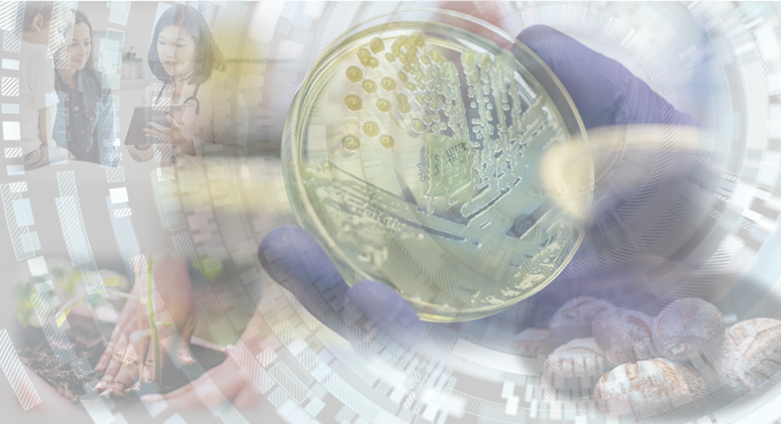

品牌服務
生技實驗服務
華安醫學股份有限公司為了促進科學研究發展,於 2007年成立實驗服務中心,由一群專業、熱心的實驗人員所組成,2015 年以前主要以蛋白質體學委託實驗服務為主,接受各方學術與醫藥單位的實驗委託,進行質譜儀或二維電泳實驗服務專案;
多年的樣品處理經驗累積及技術開發,目前我們具有多項體學(Omic)服務及科學實驗平台,並提供一站式的實驗服務,包含實驗討論諮詢、實驗服務提案、實驗流程執行、實驗數據整理與發表等級的圖表呈現,從頭到尾協助您完成實驗,提供最新最完整的實驗服務網絡。
我們專注做好實驗的每一個步驟,提供快速並值得信賴的實驗數據。
我們堅持與您討論實驗,讓您對實驗有正確的預期,因為事前討論永遠比事後檢討好。
我們希望能成為您研究版圖上的最後一塊拼圖,完整您的研究數據。